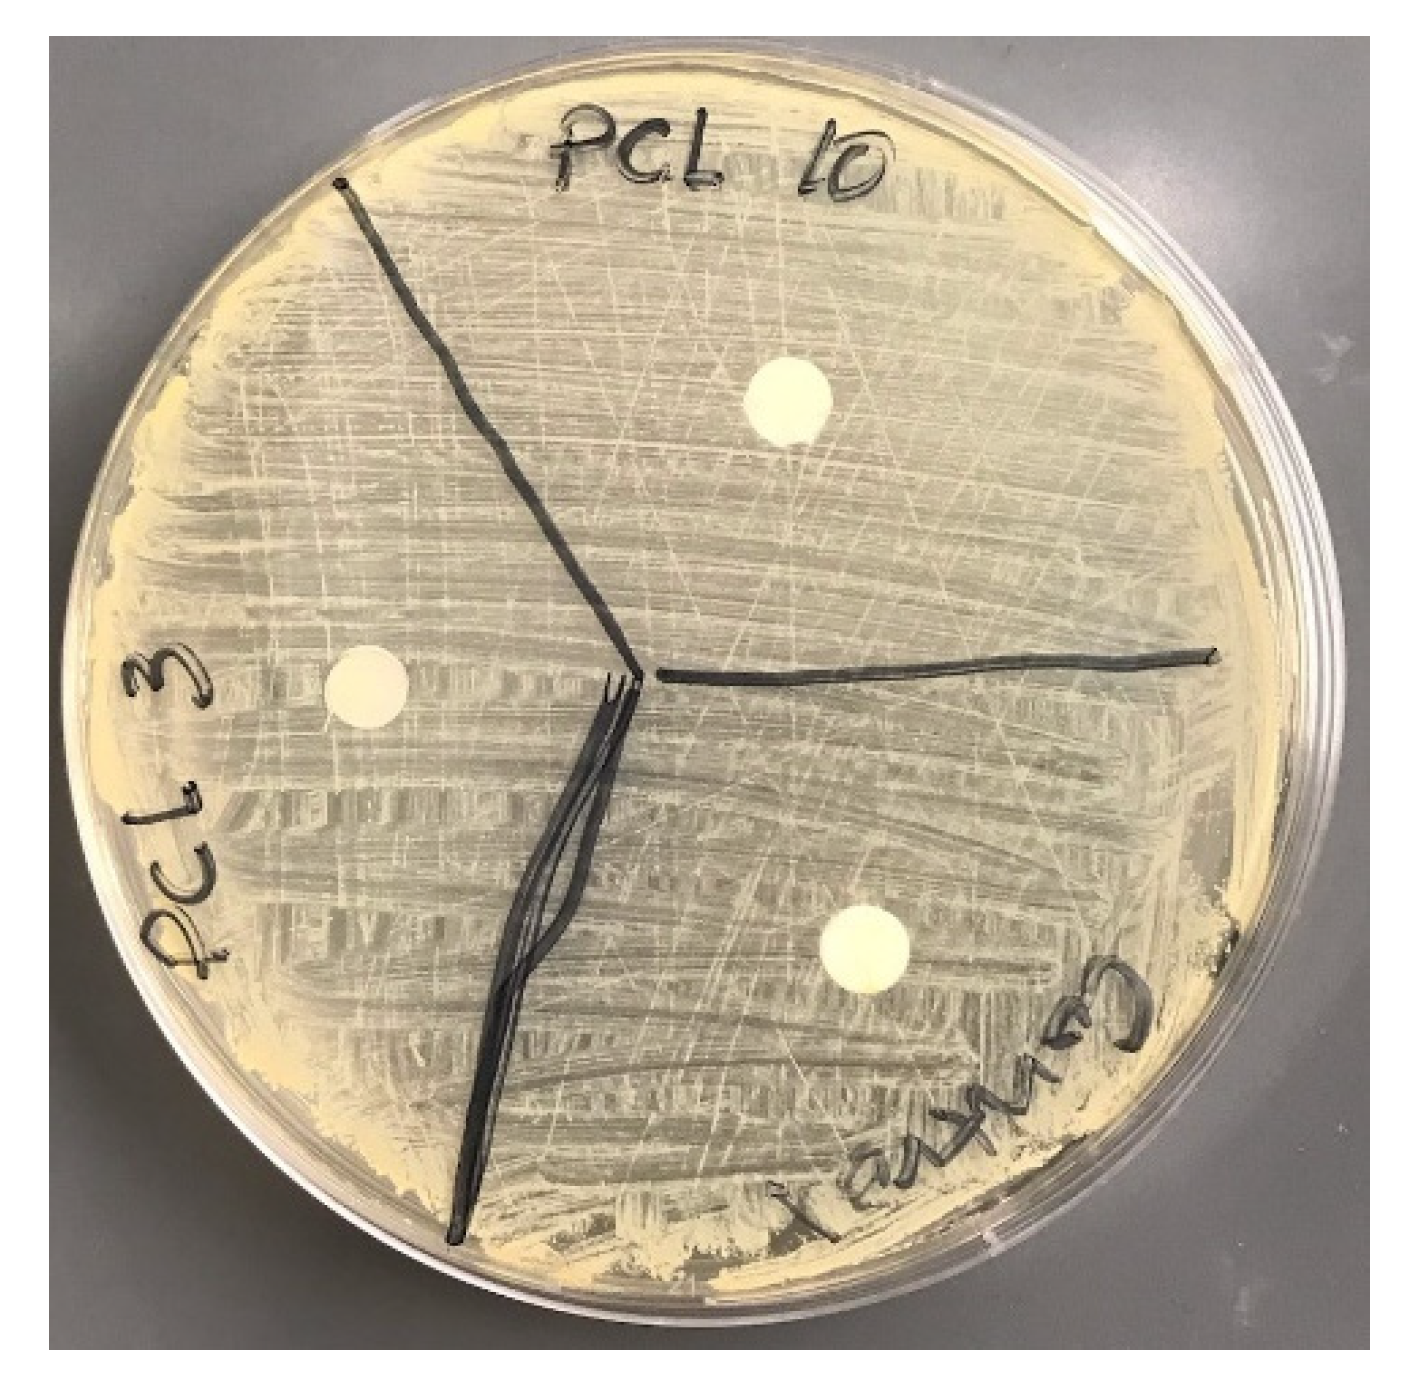
Materials 14 04272 g015

Use of Polycaprolactone Electrospun Nanofiber Mesh in a Face Mask
Abstract
:1. Introduction
2. Materials and Methods
2.1. Materials
2.2. Sample Preparation
2.3. Scanning Electron Microscope and Morphology
2.4. Contact Angle
2.5. Water Absorption
2.6. Thermal Analysis
2.7. Mechanical Tests
2.8. Filtration Analysis
2.9. Microbial Analysis
3. Results
3.1. Fabricated Samples
3.2. Morphological Analysis
3.3. Contact Angle
3.4. Water Absorption
3.5. Thermal Test
3.6. Mechanical Tests
3.7. Filtration Analysis
3.8. Microbial Analysis
4. Discussion
5. Conclusions
Author Contributions
Funding
Institutional Review Board Statement
Informed Consent Statement
Data Availability Statement
Acknowledgments
Conflicts of Interest
References
- Lausted, C.G.; Johnson, A.T.; Scott, W.H.; Johnson, M.M.; Coyne, K.M.; Coursey, D.C. Maximum static inspiratory and expiratory pressures with different lung volumes. Biomed. Eng. Online 2006, 5, 29. [Google Scholar] [CrossRef] [PubMed] [Green Version]
- Wang, H.; Hu, X.; Ke, Z.; Du, C.Z.; Zheng, L.; Wang, C.; Yuan, Z. Review: Porous Metal Filters and Membranes for Oil–Water Separation. Nanoscale Res. Lett. 2018, 13, 1–14. [Google Scholar] [CrossRef] [PubMed]
- Aydin, O.; Emon, B.; Cheng, S.; Hong, L.; Chamorro, L.P.; Saif, M.T.A. Performance of fabrics for home-made masks against the spread of COVID-19 through droplets: A quantitative mechanistic study. Extreme Mech. Lett. 2020, 40, 100924. [Google Scholar] [CrossRef]
- Bałazy, A.; Toivola, M.; Adhikari, A.; Sivasubramani, S.K.; Reponen, T.; Grinshpun, S.A. Do N95 respirators provide 95% protection level against airborne viruses, and how adequate are surgical masks? Am. J. Infect. Control 2006, 34, 51–57. [Google Scholar] [CrossRef]
- Zhou, J.; Hu, Z.; Zabihi, F.; Chen, Z.; Zhu, M. Progress and Perspective of Antiviral Protective Material. Adv. Fiber Mater. 2020, 2, 123–139. [Google Scholar] [CrossRef]
- Birkner, J. A comparison of surgical masks, surgical N95 respirators, and industrial N95 respirators. Occup. Health Saf. (Waco Tex.) 2014, 83, 14–16. [Google Scholar]
- Roberge, R.J. Evaluation of the rationale for concurrent use of N95 filtering facepiece respirators with loose-fitting powered air-purifying respirators during aerosol-generating medical procedures. Am. J. Infect. Control. 2008, 36, 135–141. [Google Scholar] [CrossRef]
- Lee, S.-A.; Hwang, D.-C.; Li, H.-Y.; Tsai, C.-F.; Chen, C.-W.; Chen, J.-K. Particle Size-Selective Assessment of Protection of European Standard FFP Respirators and Surgical Masks against Particles-Tested with Human Subjects. J. Healthc. Eng. 2016, 2016, 1–12. [Google Scholar] [CrossRef] [Green Version]
- Yim, W.; Cheng, D.; Patel, S.H.; Kou, R.; Meng, Y.S.; Jokerst, J.V. KN95 and N95 Respirators Retain Filtration Efficiency despite a Loss of Dipole Charge during Decontamination. ACS Appl. Mater. Interfaces 2020, 12, 54473–54480. [Google Scholar] [CrossRef] [PubMed]
- Liu, Y.; Ning, Z.; Chen, Y.; Guo, M.; Liu, Y.; Gali, N.K.; Sun, L.; Duan, Y.; Cai, J.; Westerdahl, D.; et al. Aerodynamic analysis of SARS-CoV-2 in two Wuhan hospitals. Nature 2020, 582, 557–560. [Google Scholar] [CrossRef] [PubMed]
- Buonanno, G.; Stabile, L.; Morawska, L. Estimation of airborne viral emission: Quanta emission rate of SARS-CoV-2 for infection risk assessment. Environ. Int. 2020, 141, 105794. [Google Scholar] [CrossRef]
- Khandaker, M.; Kotturi, H.; Progri, H.; Tummala, S.; Nikfarjam, S.; Rao, P.; Hosna, A.; Arasu, D.T.; Williams, W.; Haleem, A.M. In vitro and in vivo effect of polycaprolactone nanofiber coating on polyethylene glycol diacrylate scaffolds for intervertebral disc repair. Biomed. Mater. 2021, 16, 045024. [Google Scholar] [CrossRef]
- Malikmammadov, E.; Tanir, T.E.; Kiziltay, A.; Hasirci, V.; Hasirci, N. PCL and PCL-based materials in biomedical applications. J. Biomater. Sci. Polym. Ed. 2018, 29, 863–893. [Google Scholar] [CrossRef]
- Morais, D.S.; Guedes, R.M.; Lopes, M.A. Antimicrobial Approaches for Textiles: From Research to Market. Materials 2016, 9, 498. [Google Scholar] [CrossRef]
- Zhang, Z.; Ji, D.; He, H.; Ramakrishna, S. Electrospun ultrafine fibers for advanced face masks. Mater. Sci. Eng. R Rep. 2021, 143, 100594. [Google Scholar] [CrossRef]
- Essa, W.; Yasin, S.; Saeed, I.; Ali, G. Nanofiber-Based Face Masks and Respirators as COVID-19 Protection: A Review. Membranes 2021, 11, 250. [Google Scholar] [CrossRef] [PubMed]
- Khandaker, M.; Snow, P. Method and Apparatus for Controlled Alignment and Deposition of Branched Electrospun Fiber. International Patent Application No. AD01D500FI; U.S. Patent Application No. 9,359,694, 7 June 2016. [Google Scholar]
- Callister, W.D.; Rethwisch, D.G. Materials Science and Engineering: An Introduction; Wiley & Sons: New York, NY, USA, 2018. [Google Scholar]
- Garner, S.M.; O’Rear, E.A.; Khajotia, S.S.; Florez, F.L.E. The Applicability of a Drop Penetration Method to Measure Contact Angles on TiO2 and ZnO Nanoparticles. Nanomaterials 2020, 10, 1099. [Google Scholar] [CrossRef] [PubMed]
- Chang, B.; Sharma, R.S.; Huynh, T.; Kudrolli, A. Aerial mucosalivary droplet dispersal distributions with implications for disease mitigation. Phys. Rev. Res. 2020, 2, 043391. [Google Scholar] [CrossRef]
- Lyu, J.S.; Lee, J.-S.; Han, J. Development of a biodegradable polycaprolactone film incorporated with an antimicrobial agent via an extrusion process. Sci. Rep. 2019, 9, 1–11. [Google Scholar] [CrossRef] [PubMed]
- Chua, M.H.; Cheng, W.; Goh, S.S.; Kong, J.; Li, B.; Lim, J.Y.C.; Mao, L.; Wang, S.; Xue, K.; Yang, L.; et al. Face Masks in the New COVID-19 Normal: Materials, Testing, and Perspectives. Research 2020, 2020, 7286735. [Google Scholar] [CrossRef] [PubMed]
- Gram-Molecular Weight. The Columbia Encyclopedia, t.e.R.A., 2021 from Encyclopedia.com. Available online: https://www.encyclopedia.com/reference/encyclopedias-almanacs-transcripts-and-maps/gram-molecular-weight (accessed on 3 June 2020).
- Kilmartin-Lynch, S.; Saberian, M.; Li, J.; Roychand, R.; Zhang, G. Preliminary evaluation of the feasibility of using polypropylene fibres from COVID-19 single-use face masks to improve the mechanical properties of concrete. J. Clean. Prod. 2021, 296, 126460. [Google Scholar] [CrossRef] [PubMed]
- Battegazzore, D.; Cravero, F.; Frache, A. Is it Possible to Mechanical Recycle the Materials of the Disposable Filtering Masks? Polymers 2020, 12, 2726. [Google Scholar] [CrossRef] [PubMed]
- Yin, Y.; Pu, D.; Xiong, J. Analysis of the Comprehensive Tensile Relationship in Electrospun Silk Fibroin/Polycaprolactone Nanofiber Membranes. Membranes 2017, 7, 67. [Google Scholar] [CrossRef] [PubMed] [Green Version]
- Nguyen, N.Q.; Chen, T.-F.; Lo, C.-T. Confined crystallization and chain conformational change in electrospun poly(ethylene oxide) nanofibers. Polym. J. 2021, 53, 1–11. [Google Scholar] [CrossRef]
- Fang, Z.; Ouyang, Z.; Zheng, H.; Wang, X.; Hu, L. Culturable Airborne Bacteria in Outdoor Environments in Beijing, China. Microb. Ecol. 2007, 54, 487–496. [Google Scholar] [CrossRef]
- Tsai, F.C.; Macher, J.M. Concentrations of airborne culturable bacteria in 100 large US office buildings from the BASE study. Indoor Air 2005, 15, 71–81. [Google Scholar] [CrossRef] [PubMed]
- Nikfarjam, S.; Alkhaleeli, R.; Khandaker, M. Antibacterial Properties of MgO Nanoparticles Immobilized Polycaprolactone to Staphylococcus Aureus. In Proceedings of the Annual Meeting Orthopaedic Research Society, Austin, TX, USA, 2–5 February 2019. [Google Scholar]

| Specimen Type | Pore Sizes (Micrometer) |
|---|---|
| Surgical Mask | 5.71 ± 3.41 |
| PCL-3 | 4.65 ± 2.09 |
| PCL-10 | 1.42 ± 0.34 * |
| Experimental Parameters | Control | PCL-3 | PCL-10 |
|---|---|---|---|
| Young’s Modulus (MPa) | 15.34 ± 2.86 | 18.18 ± 4.41 | 33.96 ± 5.77 * |
| Tensile strength (MPa) | 1.49 ± 0.29 | 4.96 ± 0.19 * | 6.33 ± 0.78 * |
Publisher’s Note: MDPI stays neutral with regard to jurisdictional claims in published maps and institutional affiliations. |
© 2021 by the authors. Licensee MDPI, Basel, Switzerland. This article is an open access article distributed under the terms and conditions of the Creative Commons Attribution (CC BY) license (https://creativecommons.org/licenses/by/4.0/).
Share and Cite
Khandaker, M.; Progri, H.; Arasu, D.T.; Nikfarjam, S.; Shamim, N. Use of Polycaprolactone Electrospun Nanofiber Mesh in a Face Mask. Materials 2021, 14, 4272. https://doi.org/10.3390/ma14154272
Khandaker M, Progri H, Arasu DT, Nikfarjam S, Shamim N. Use of Polycaprolactone Electrospun Nanofiber Mesh in a Face Mask. Materials. 2021; 14(15):4272. https://doi.org/10.3390/ma14154272
Chicago/Turabian StyleKhandaker, Morshed, Helga Progri, Dhakshyane Tamil Arasu, Sadegh Nikfarjam, and Nabila Shamim. 2021. "Use of Polycaprolactone Electrospun Nanofiber Mesh in a Face Mask" Materials 14, no. 15: 4272. https://doi.org/10.3390/ma14154272
APA StyleKhandaker, M., Progri, H., Arasu, D. T., Nikfarjam, S., & Shamim, N. (2021). Use of Polycaprolactone Electrospun Nanofiber Mesh in a Face Mask. Materials, 14(15), 4272. https://doi.org/10.3390/ma14154272

